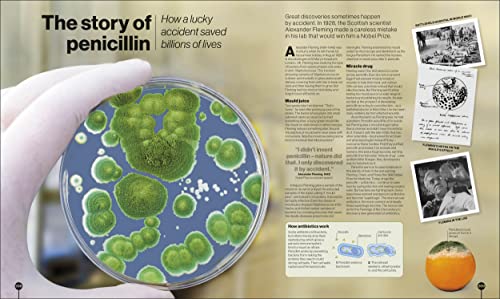
Timelines of Science - Retail Maharaj

Timelines of Science
Timelines of Science is backordered and will ship as soon as it is back in stock.
Couldn't load pickup availability
Genuine Products Guarantee
Genuine Products Guarantee
We guarantee 100% genuine products, and if proven otherwise, we will compensate you with 10 times the product's cost.
Delivery and Shipping
Delivery and Shipping
Products are generally ready for dispatch within 1 day and typically reach you in 3 to 5 days.
Author: DK
Brand: DK
Binding: Hardcover
Number Of Pages: 320
Release Date: 06-10-2022
Part Number: 9780241515358
Details: Explore spectacular visual timelines that tell the story of science, from fossils to quantum physics, and discover exactly how science has changed the world - one discovery at a time.
Timelines of Science takes you on an astonishing journey through history, showing how dedication, disasters, and eureka moments have brought us antibiotics, electricity, space exploration, and so much more!
Packed with fascinating facts, amazing images, and some seriously staggering science, this science history book shows how thousands of years of human endeavour have expanded our knowledge and shaped our lives. Find out why the fruitless search for a potion of eternal life led to the birth to chemistry. See how the invention of magnifying lenses opened new windows into the cosmos and micro-cosmos. And learn how happy accidents led to the discovery of X-rays, batteries, pulsars, and even the big bang.
Dive deep into the pages of this sublime science book to discover:
- Timeline features show how scientific ideas developed over time
- Easy-to-read explanations of general science topics, such as the life cycle of a star or the history of Earth's changing climate
- Supporting boxes explain modern scientific concepts, adding educational value and aiding understanding
- Feature spreads highlight specific breakthroughs, with the story presented as running text in a newspaper-style layout
- Biographies showcase the lives of key men and women who reshaped scientific thought
Timelines of Science is not just about science - it's also a book about people! The stories of discovery are told through the lives of extraordinary men and women who often dared to challenge conventional wisdom in their trailblazing pursuit of scientific truth.
Filled with dazzling illustrations, spectacular photography, and easy-to-follow storytelling, Timelines of Science is guaranteed to capture the imagination of children and adults of all ages and abilities.
A must-have volume for children 9+ interested in science, technology, and invention, doubling up as the perfect gift to for budding scientists, Timelines of Science is sure to delight.
Explore the series!
If you like Timelines of Science, why not check out other our exciting titles in the Timelines series? Explore the unique collection of visual timelines which bring big topics to life. Discover leaders, legends and legacies in Timelines of Black History, uncover the past from woolly mammoths to World Wars in Timelines of Everything and explore the natural world through time with Timelines of Nature.
EAN: 9780241515358
Package Dimensions: 11.3 x 9.6 x 1.0 inches
Languages: English